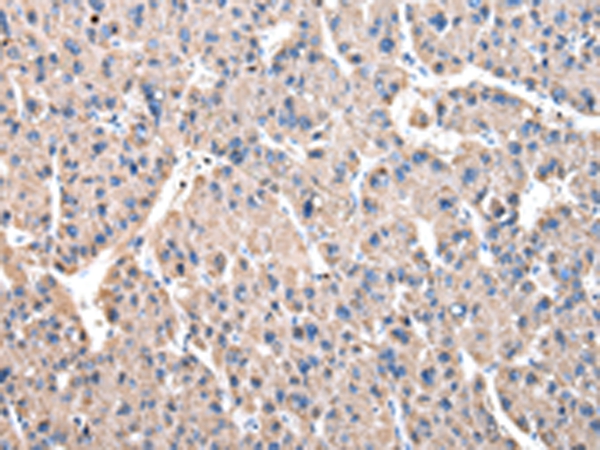

-
分类: 科研抗体货号: P43446别名: ANOP3; MCOPS3应用: WB,IHC反应种属: Human
-
分类: 科研抗体货号: P43430别名: GDH; G6PDH; CORTRD1应用: WB,IHC反应种属: Human,Mouse
-
分类: 科研抗体货号: P43435别名: HBSL; aspRS应用: WB,IHC反应种属: Human
-
分类: 科研抗体货号: P43444别名: 6-phosphofructo-2-kinase; 6-phosphofructo-2-kinase/fructose-2,6-biphosphatase 4; 6-phosphofructo-2-kinase/fructose-2,6-biphosphatase-4; 6PF-2-K/Fru-2,6-P2ase 4应用: WB,IHC反应种属: Human
-
分类: 科研抗体货号: P43428别名: FACT; T160; FACT80应用: WB,IHC反应种属: Human
-
分类: 科研抗体货号: P43434别名: CCTE; HEL-S-69; CCT-epsilon; TCP-1-epsilon应用: WB,IHC反应种属: Human,Mouse
-
分类: 科研抗体货号: P43443别名: Mar1; HsMar1; METNASE应用: WB,IHC反应种属: Human
-
分类: 科研抗体货号: P43427别名: P47应用: WB,IHC反应种属: Human
-
分类: 科研抗体货号: P43462别名: SPI-C应用: WB,IHC反应种属: Human,Mouse
-
分类: 科研抗体货号: P43442别名: FIR; VRJS; RoBPI; SIAHBP1应用: WB,IHC反应种属: Human,Mouse

鄂公网安备42018502007531号
鄂公网安备42018502007531号

